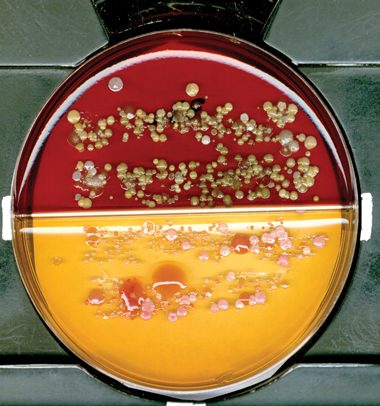

It is well known that hospital pathogens can be transmitted from the hands of health care workers (HCWs) to patients.1 This may occur through direct contact with the patient or indirectly, via an inanimate object. Many articles of clothing and equipment, such as neckties,2-9 doctors’ coats,10-12 stethoscopes13-17 and pens,18,19 have been noted to carry potential pathogens.
Items such as the ends of neckties have been suggested as potential sources of nosocomial infection because of their position at waist level, their tendency to swing freely as the wearer leans forward and the fact that many are not machine-washable. Most are capable of being colonised with bacteria, including pathogens such as methicillin-resistant Staphylococcus aureus (MRSA).4,20 Similarly, plastic identity badges attached to fabric lanyards hang around the front of the body, where, because of their pendulous nature, they can come into contact with patients and may act as a source of infection (Box 1).
Four samples were collected from each HCW:
direct imprints of two 9 cm lengths of the lower lanyard;
a saline-moistened swab of the front and back surfaces of the identity badge;
a saline-moistened swab of the distal edge of the identity badge; and
a swab of “connections” (additional items carried on lanyards — eg, clips, keys, pens) (Box 2).
The number and type of pathogens recovered from identity badges and lanyards are shown in Box 4. Of the connection swabs, five had MSSA and two had Enterococcus spp; of the swabs from the distal edge of identity badges, seven had MSSA, one had MRSA, one had Enterococcus spp, and one had GNB. Enterococci were identified as E. casseliflavus, E. gallinarum and E. faecium, and none were found to be vancomycin-resistant. GNB were identified as Escherichia coli, Klebsiella spp (Box 5) and Enterobacter spp.
Pathogenic bacteria recovered from ward patients with clinical infections during our study were similar to those isolated from identity badges and lanyards (Box 6). Patients with MSSA and MRSA clinical isolates were present in all the wards surveyed. The predominant gram-negative clinical isolates were E. coli and Klebsiella spp.
A comparison of the RRs of isolating pathogens from the identity badges or lanyards of nurses and doctors (adjusted for ward location) is shown in Box 7. Doctors were found to have over four times the risk of carrying MSSA on lanyards compared with nurses (RR, 4.41; 95% CI, 1.41–13.75; P = 0.01). There were no differences detected for identity badges.
Previous studies have documented that potential pathogens can be recovered from many articles of clothing worn by HCWs. The organisms identified have mainly been skin commensals (including MSSA), but two studies have detected MRSA on doctors’ neckties4,9 and another detected MRSA on the membranes of physicians’ stethoscopes.16
Bacterial contamination of HCWs’ clothing and equipment may often come indirectly from the hospital environment rather than from infected patients.21 Contaminated clothing or equipment provides a reservoir from which HCWs may reinoculate their hands, even after hand hygiene procedures have been performed, thus allowing transmission of pathogens to patients or the environment. The British Medical Association (BMA) has suggested that doctors refrain from wearing non-essential items of clothing, such as ties, as they have the potential to act as a vector for the transmission of infections.22 However, the evidence supporting the BMA recommendation is limited. Although potential pathogens such as S. aureus have been isolated from doctors’ neckties,20 in most studies only a small number of ties were tested.
Lanyards and identity badges are worn by both male and female clinical staff for long periods of time without cleaning. Their position at waist level and their pendulous nature increase the risk that they will become contaminated. Studies have shown that bacteria survive for long periods on hospital fabrics and plastic surfaces, with gram-negative bacteria surviving for over 60 days and enterococci and staphylococci for over 90 days.23,24 Patients with MSSA, MRSA, Enterococcus spp and GNB infections were present in all three wards included in our study, and these typical hospital pathogens were recovered from identity badges and lanyards.
Our study showed that doctors are four times more likely than nurses to carry MSSA on their lanyards. A recent observational study by Pittet et al25 showed that compliance with hand hygiene protocols is low among doctors compared with nurses, and this may help to explain the greater contamination of doctors’ lanyards with hospital pathogens in our study. However, further larger studies are required to compare the carriage rate of potential pathogens by doctors and nurses.
One limitation of our study is that we did not assess HCWs for carriage of S. aureus in the nares or on the hands, and so could not correlate this with S. aureus isolated from the lanyard set. Although HCWs estimated how long they had used the lanyards, we were unable to establish at what point they became contaminated with pathogens. The literature suggests that a steady state of maximum contamination is reached quickly and does not significantly change thereafter.10 A prospective study to determine the timing of acquisition and duration of bacterial contamination in a clinical setting may be useful.
5 Lanyard imprint on agar plate
![]() |
|
Large pink mucoid colonies of Klebsiella spp are visible on MacConkey agar. |
6 Number of patients with clinical isolates during the study period, by unit
MRSA = methicillin-resistant Staphylococcus aureus. MSSA = methicillin-sensitive S. aureus. |
|||||||||||||||
Received 24 April 2007, accepted 25 September 2007
- Despina Kotsanas1
- Carmel Scott2
- Elizabeth E Gillespie2
- Tony M Korman1,3
- Rhonda L Stuart1,2
- 1 Department of Infectious Diseases, Southern Health — Monash Medical Centre, Melbourne, VIC.
- 2 Department of Infection Control and Epidemiology, Southern Health — Monash Medical Centre, Melbourne, VIC.
- 3 Department of Medicine, Monash University, Melbourne, VIC.
We would like to thank Associate Professor Damien Jolley (Senior Biostatistician) for his advice on our statistical analysis.
None identified.
- 1. Boyce JM, Pittet D; Healthcare Infection Control Practices Advisory Committee. Society for Healthcare Epidemiology of America. Association for Professionals in Infection Control. Infectious Diseases Society of America. Hand Hygiene Task Force. Guideline for hand hygiene in health-care settings: recommendations of the Healthcare Infection Control Practices Advisory Committee and the HICPAC/SHEA/APIC/IDSA Hand Hygiene Task Force. Infect Control Hosp Epidemiol 2002; 23 (12 Suppl): S3-S40.
- 2. Jameson M. Dirty ties. Br J Perioper Nurs 2004; 14: 332.
- 3. Dixon M. Neck ties as vectors for nosocomial infection. Intensive Care Med 2000; 26: 250.
- 4. Ditchburn I. Should doctors wear ties? J Hosp Infect 2006; 63: 227-228.
- 5. Nurkin S. Is the clinicians’ necktie a potential fomite for hospital acquired infections [abstract]? 104th General Meeting of the American Society for Microbiology; 2004 May 23-27; New Orleans, La, USA.
- 6. Day M. Doctors are told to ditch “disease spreading” neckties. BMJ 2006; 332: 442.
- 7. Biljan MM, Hart CA, Sunderland D, et al. Multicentre randomised double blind crossover trial on contamination of conventional ties and bow ties in routine obstetric and gynaecological practice. BMJ 1993; 307: 1582-1584.
- 8. Steinlechner C, Wilding G, Cumberland N. Microbes on ties: do they correlate with wound infection? Ann R Coll Surg Engl 2002; 84 (Suppl): 307-309.
- 9. Bhattacharya S. Doctors’ ties harbour disease-causing germs [Internet]. NewScientist.com 2004; 24 May. http://www.newscientist.com/article/dn5029-doctors-ties-harbour-diseasecausing-germs.html (accessed Oct 2007).
- 10. Wong D, Nye K, Hollis P. Microbial flora on doctors’ white coats. BMJ 1991; 303: 1602-1604.
- 11. Loh W, Ng VV, Holton J. Bacterial flora on the white coats of medical students. J Hosp Infect 2000; 45: 65-68.
- 12. Sundeep S, Allen KD. An audit of the dress code for hospital medical staff. J Hosp Infect 2006; 64: 92-93.
- 13. Marinella MA, Pierson C, Chenoweth C. The stethoscope. A potential source of nosocomial infection? Arch Intern Med 1997; 157: 786-790.
- 14. Bernard L, Kereveur A, Durand D, et al. Bacterial contamination of hospital physicians’ stethoscopes. Infect Control Hosp Epidemiol 1999; 20: 626-628.
- 15. Varghese D, Patel H. Hand washing. Stethoscopes and white coats are sources of nosocomial infection. BMJ 1999; 319: 519.
- 16. Madar R, Novakova E, Baska T. The role of non-critical health-care tools in the transmission of nosocomial infections. Bratisl Lek Listy 2005; 106: 348-350.
- 17. Kennedy KJ, Dreimanis DE, Beckingham WD, Bowden FJ. Staphylococcus aureus and stethoscopes [letter]. Med J Aust 2003; 178: 468. <MJA full text>
- 18. French G, Rayner D, Branson M, Walsh M. Contamination of doctors’ and nurses’ pens with nosocomial pathogens. Lancet 1998; 351: 213.
- 19. Datz C, Jungwirth A, Dusch H, et al. What’s on doctors’ ball point pens? Lancet 1997; 350: 1824.
- 20. Lintott P, Parry D. Let’s lose the tie. J Hosp Infect 2001; 48: 81-82.
- 21. Boyce JM, Potter-Bynoe G, Chenevert C, King T. Environmental contamination due to methicillin-resistant Staphylococcus aureus: possible infection control implications. Infect Control Hosp Epidemiol 1997; 18: 622-627.
- 22. British Medical Association. Health care associated infections. A guide for healthcare professionals. London: BMA, 2006: 13. http://www.bma.org.uk/ap.nsf/AttachmentsByTitle/PDFHealthcareAssocInfect/$FILE/HCAIs.pdf (accessed Oct 2007).
- 23. Neely AN, Maley MP. Survival of enterococci and staphylococci on hospital fabrics and plastic. J Clin Microbiol 2000; 38: 724-726.
- 24. Neely A. A survey of gram-negative bacteria survival on hospital fabrics and plastics. J Burn Care Rehabil 2000; 21: 523-527.
- 25. Pittet D, Hugonnet S, Harbarth S, et al. Effectiveness of a hospital-wide programme to improve compliance with hand hygiene. Infection Control Programme. Lancet 2000; 356: 1307-1312.

Abstract
Objective: To determine whether identity badges and lanyards worn by health care workers (HCWs) are capable of harbouring potentially pathogenic bacteria.
Design, setting and participants: Cross-sectional study of 71 HCWs (59 clinical ward staff and 12 infection control staff) at Monash Medical Centre, a university teaching hospital. Samples from lanyards, identity badge surfaces and connections (eg, clips, keys, pens) were cultured. The study was conducted from July to August 2006.
Main outcome measures: Presence of pathogenic bacteria on identity badges and lanyards; differences in bacterial counts on items carried by nurses and doctors.
Results: A total of 27 lanyards were identified with pathogenic bacteria, compared with 18 badges. Analysing lanyards and badges as a combined group, seven had methicillin-resistant Staphylococcus aureus, 29 had methicillin-sensitive S. aureus (MSSA), four had Enterococcus spp and five had aerobic gram-negative bacilli. Lanyards were found to be contaminated with 10 times the median bacterial load per area sampled compared with identity badges. There were no significant differences between nurses and doctors in total median bacterial counts on items carried, but doctors had 4.41 times the risk of carrying MSSA on lanyards (95% CI, 1.14–13.75).
Conclusion: Identity badges and lanyards worn by HCWs may be contaminated with pathogenic bacteria, which could be transmitted to patients. In view of this finding we suggest appropriate infection control interventions.